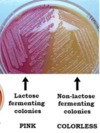

<p>Neisseria Meningitidis - meningitis and septicaemia</p>
<p>Neisseria ghonorrhoeae - urethritis in men - pelvic inflammatory disease</p>
<p>What are the forms of Neisseria spp that are of clinical significance?</p>
<p>Aerobic gram negative cocci</p>

<p>What type of bacteria are Neisseria spp and Moraxella catarrhalis?</p>
<p>Can't be stained with gram stains</p>
<p>Can't be cultured under standard methods Mycobacterium Spirochaetes Chlamydia</p>
<p>What is meant by miscellaneous bacteria</p>
<p>Does salmonella ferment lactose?</p>
<p>NO</p>
<p>Yes</p>
<p>Does E Coli ferment lactose?</p>
<p>Klebsiella - UTI and pneumonia</p>
<p>Proteus spp - UTI</p>

<p>What other commensals of the gut exist? (apart from E.Coli)</p>
<p>NO</p>
<p>Does salmonella ferment lactose?</p>
<p>What type of organisms is pseudomonas?</p>
<p>Strict aerobic bacilli water and soil organisms</p>
<p>Contaminates medical equipment</p>
<p>Hospital acquired cause of sepsis: pneumonia, UTI Respiratory infection in cystic fibrosis</p>

<p>What causes tuberculosis?</p>
<p>Mycobacterium tuberculosis</p>
<p>Large (coliforms)</p>
<p></p>
<p>Small</p>
<p>What are the sub divisions of gram negative aerobic bacilli?</p>
<p>What is the test for syphilis?</p>
<p>Serology, nucleic amplification tests</p>
<p>What type of organism is E.Coli?</p>
<p>Coliform - large gram negative aerobic bacilli</p>
<p>Treponem pallidum - syphilis</p>
<p>Borrelia burgdorferi - lymes disease</p>

<p>Give an example of a spirochaetes</p>

<p>Bacteriodes Fragilis - normal colonic flora</p>
<p></p>
<p>Causes intra-abdominal abscess</p>

<p>What are the important anaerobes? (BACILLI)</p>
<p>Primary - Non-painful skin legions</p>
<p>Secondary - Systemic illness and rash</p>
<p>Latent - symptomatic episodes may occur</p>
<p>Tertiary - central nervous system Congenital - stillbirth, neonatal death or disease</p>
<p>What are the stages of syphilis?</p>
<p>Prevotella - cause of dental abscess (pus that forms in the teeth and gums), aspiration pneumonia, human and animal bite infections.</p>
<p></p>
<p></p>

<p>Name an oral anaerobe</p>
<p>What are the strains of chlamydia that cause respiratory infection?</p>
<p>Chlamydophila pneumoniae</p>
<p>Chlamydophila psittaci - contact with birds</p>
<p>Urinary tract infection</p>
<p>Enterotoxogenic E.Coli - commonest cause of travellers diarrhoea</p>
<p>Enterohaemorrhagic E.coli - Bloody diarrhoea Haemolytic uraemic syndrome</p>
<p>What is the infection usually associated with Ecoli?</p>
<p>Gut pathogen Coliform</p>
<p>What type of organism is salmonella?</p>
<p>Name a microaerophilic spiral bacilli</p>
<p>Helicobacter pylori - natural habitat is human stomach - damages mucosa and causes ulcers</p>
<p></p>
<p></p>

<p>Mycobacterium leprae</p>
<p>What causes leprosy?</p>
<p>What causes leprosy?</p>
<p>Mycobacterium leprae</p>
<p>What is the ZN stain used for?</p>
<p>Mycobacterium species</p>

<p>What family do Coliforms belong in?</p>
<p>EnterobacteriaceaeInhabitants of the gut</p>
What strain of chlamydia is responsible for the Ophthalmic and genital tract infection?
Chlamydia trachomatis - trachoma (tropical eye infections) Can lead to pelvic inflammatory disease and infertility

What does salmonella cause?
Enterocollitis, with or without bloody diarrhoea

What does typhoid cause?
Fever and constipation
Serology, nucleic amplification tests
What is the test for syphilis?
What are the sub divisions of gram negative aerobic bacilli?
Large (coliforms)
Small
Mycobacterium tuberculosis
What causes tuberculosis?
What type of organism is salmonella?
Gut pathogen Coliform
Coliform - large gram negative aerobic bacilli
What type of organism is E.Coli?
Obligate intracellular bacteria
What type of bacteria is chlamydia?
What type of bacteria is chlamydia?
Obligate intracellular bacteria
1. Skin rash
2. Systemic illness - cardiac or neurological and musculoskeletal symptoms
3. Chronic disease - skin, nervous system or joint abnormalities
What are the stages of lymes disease?
Present from birth
Define congenital
Enterocollitis, with or without bloody diarrhoea

What does salmonella cause?
Give an example of a spirochaetes

Treponem pallidum - syphilis
Borrelia burgdorferi - lymes disease

What does Moraxella Catarrhalis cause?
Respiratory tract infections
Helicobacter pylori - natural habitat is human stomach - damages mucosa and causes ulcers

Name a microaerophilic spiral bacilli
What are the virulence mechanisms of Escherichia coli?
pili, capsule, endotoxin and exotoxins produced

Lactose fermentation
What is the test for gram negative bacilli?
What does microaerophilic mean?
Requires little free oxygen
Strict aerobic bacilli water and soil organisms
Contaminates medical equipment
Hospital acquired cause of sepsis: pneumonia, UTI Respiratory infection in cystic fibrosis

What type of organisms is pseudomonas?
Fever and constipation
What does typhoid cause?
What are the important anaerobes? (BACILLI)
Bacteriodes Fragilis - normal colonic flora
Causes intra-abdominal abscess
Define congenital
Present from birth
What are the gram negative bacilli other than coliforms?
Bordetella pertusis - whooping cough
Haemophilus infuenzae - cocco bacilli (mixed appearance) respiratory tract infection - capsulate form formerly an important cause of meningitis

What is meant by miscellaneous bacteria
Can't be stained with gram stains
Can't be cultured under standard methods Mycobacterium Spirochaetes Chlamydia
Respiratory tract infections
What does Moraxella Catarrhalis cause?
Salmonella typhi

What is the cause of typhoid fever?
What is the test for gram negative bacilli?
Lactose fermentation
Campylobacter - commonest cause of bacterial diarrhoea in the UK

Name a curved microaerophilic gram negative bacilli
Name a curved microaerophilic gram negative bacilli
Campylobacter - commonest cause of bacterial diarrhoea in the UK
Chlamydophila pneumoniae
Chlamydophila psittaci - contact with birds
What are the strains of chlamydia that cause respiratory infection?
How is diagnosis of chlamydia achieved?
Nucleic acids amplification tests
What are the stages of lymes disease?
1. Skin rash
2. Systemic illness - cardiac or neurological and musculoskeletal symptoms
3. Chronic disease - skin, nervous system or joint abnormalities
What are the forms of Neisseria spp that are of clinical significance?
Neisseria Meningitidis - meningitis and septicaemia
Neisseria ghonorrhoeae - urethritis in men - pelvic inflammatory disease
What are the stages of syphilis?
Primary - Non-painful skin legions
Secondary - Systemic illness and rash
Latent - symptomatic episodes may occur
Tertiary - central nervous system Congenital - stillbirth, neonatal death or disease
What type of bacteria are Neisseria spp and Moraxella catarrhalis?

Aerobic gram negative cocci
Does E Coli ferment lactose?
Yes
What is used to detect spirochaetes?
Dark ground microscopy or immunofluorescence - Often diagnosed by serology

Mycobacterium species

What is the ZN stain used for?
What is the cause of typhoid fever?
Salmonella typhi

What other commensals of the gut exist? (apart from E.Coli)

Klebsiella - UTI and pneumonia
Proteus spp - UTI
Bordetella pertusis - whooping cough
Haemophilus infuenzae - cocco bacilli (mixed appearance) respiratory tract infection - capsulate form formerly an important cause of meningitis
What are the gram negative bacilli other than coliforms?

Name an oral anaerobe
Prevotella - cause of dental abscess (pus that forms in the teeth and gums), aspiration pneumonia, human and animal bite infections.

Name another gut pathogen that isn't salmonella or E.Coli

Shigella - diarrhoea, dysentery
Chlamydia trachomatis - trachoma (tropical eye infections) Can lead to pelvic inflammatory disease and infertility

What strain of chlamydia is responsible for the Ophthalmic and genital tract infection?
EnterobacteriaceaeInhabitants of the gut
What family do Coliforms belong in?
What is the infection usually associated with Ecoli?
Urinary tract infection
Enterotoxogenic E.Coli - commonest cause of travellers diarrhoea
Enterohaemorrhagic E.coli - Bloody diarrhoea Haemolytic uraemic syndrome
Dark ground microscopy or immunofluorescence - Often diagnosed by serology

What is used to detect spirochaetes?
pili, capsule, endotoxin and exotoxins produced

What are the virulence mechanisms of Escherichia coli?
Requires little free oxygen
What does microaerophilic mean?
Shigella - diarrhoea, dysentery
Name another gut pathogen that isn't salmonella or E.Coli
Nucleic acids amplification tests
How is diagnosis of chlamydia achieved?


